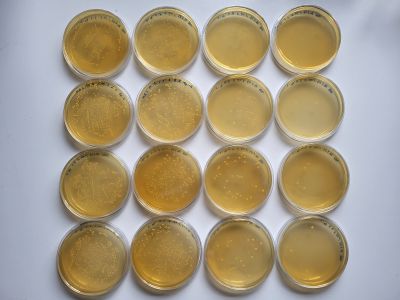
agarplatten-mit-kolonien

FERMENTIERUNG UND MIKROVERKAPSELUNG VON FUTTERMITTELZUSATZSTOFFEN
Verbesserung der biologischen Wirksamkeit von Pflanzenstoffen für die Tiergesundheit
Agarplatten mit Kolonien
Foto: Alice König

Bioreaktor für die Fermentation
Foto: Alice König

Fermentierte Zitrusschalen
Foto: Alice König
Die Tiergesundheit spielt eine wesentliche Rolle bei der Gewinnung von hochwertigem Fleisch, Milchprodukten und Eiern. Vor allem junge Tiere sind jedoch sehr anfällig für Infektionen und Krankheiten. Bestimmte pflanzliche Wirkstoffe („bioaktive Wirkstoffe“ oder „Phytochemikalien“ genannt) können die Darmgesundheit und Wachstumsleistung von Nutztieren verbessern und deren Widerstandsfähigkeiten gegen Krankheiten erhöhen, weshalb sie als Futtermittelzusatzstoffe eingesetzt werden.
Viele Pflanzen speichern ihre aktiven Chemikalien in Form inaktiver Glykoside, bei denen Zuckermoleküle an die funktionellen Gruppen (die chemisch aktiven Teile) der bioaktiven Moleküle gebunden sind. Die Pflanze entfernt diese Zucker und aktiviert so die Chemikalien, wenn sie benötigt werden, mit ihren eigenen Enzymen. Wenn bioaktive Verbindungen aus Pflanzen extrahiert werden, erhält man größtenteils die inaktive glykosylierte Form.
Um eine biologische Aktivität im Tier zu entfalten, müssen die dem Futter zugesetzten bioaktiven Inhaltsstoffe die Darmbarriere passieren und am Wirkungsort verfügbar sein. Jedoch limitieren glykosidische Bindungen bei vielen Pflanzenstoffen die Resorption im Darm und reduzieren folglich die gesundheitsfördernden Eigenschaften. Da im tierischen Darm die zur Hydrolyse der Zucker erforderlichen pflanzlichen Enzyme nicht vorliegen, muss man daher andere Methoden anwenden, um die Zucker von der glykosylierten, inaktiven Form des pflanzlichen Wirkstoffes zu entfernen und dessen Resorption im Darm zu verbessern.
Ziel dieses Projekts ist die Etablierung einer Methode zur Freisetzung bioaktiver pflanzlicher Substanzen in glykosidischer Bindung mittels mikrobieller Spaltung, um ihre Bioverfügbarkeit und biologische Wirksamkeit zu erhöhen. Ausgewählte Pflanzenstoffe sollen analytisch charakterisiert und zur Abspaltung der Zuckerverbindungen fermentiert werden. Zunächst werden Fermentationsversuche im kleinen Maßstab durchgeführt, um die optimalen Parameter zu ermitteln. Sobald geeignete Bakterienstämme sowie die richtigen Fermentationsparameter identifiziert sind, kann der ausgewählte Rohstoff in einem kleinen Bioreaktor fermentiert werden. Darüber hinaus soll die Wirksamkeit fermentierter und/oder mikroverkapselter Substanzen in geeigneten in-vitro und in-vivo Modellen untersucht werden. Bei der Mikroverkapselung werden Substanzen in eine Matrix eingebettet, um kleine Kapseln zu bilden. Temperatur, saures Milieu oder Enzyme können dann die Freisetzung der bioaktiven Komponente im Gastrointestinaltrakt auslösen. Im Vordergrund steht der Erkenntnisgewinn in Bezug auf die Machbarkeit und Effizienz der eingesetzten Technologien, um die biologische Aktivität von pflanzlichen Futtermittelzusatzstoffen zu erhöhen.
Lead Researcher:

FH-Prof. Priv.-Doz. Dr. Julian Weghuber
FFoQSI Area Leader GREEN
Leiter CoE Lebensmitteltechnologie und Ernährung
Lebensmitteltechnologie und Ernährung an der FH Oberösterreich
julian.weghuber@fh-wels.at
+43 5 0804 44403
www.fh-ooe.at



